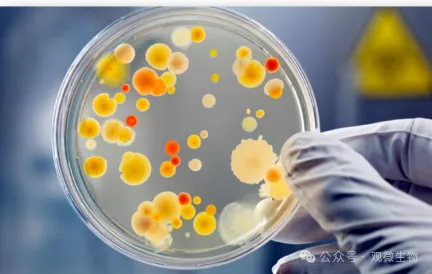

在农业微生物菌剂的生产过程中,有一种“隐形杀手”常常让技术员夜不能寐——
噬菌体污染。
它能在不经意间侵入接种台、培养区、发酵系统,造成菌种大规模崩溃,甚至整批产品报废;与此同时,空气中漂浮的杂菌也在悄无声息中干扰你的无菌操作流程,成为影响产率与质量的“幕后黑手”。
在努力做科研、拼生产的同时,你是否也遇到过这些困扰?

痛点一:空气杂菌超标,干扰发酵与菌种稳定性
即使严格执行无菌操作、设有洁净区,仍无法完全隔绝空气中的杂菌污染:
- 空调换风系统不稳定,空气循环带来二次污染;
- 培养间/接种间残留真菌孢子、芽孢杆菌等杂菌,竞争营养;
- 灰尘与气溶胶中夹带的噬菌体颗粒,轻松突破防线侵入培养体系。
看不见的空气污染,常常是你产量“掉线”的真正原因。
痛点二:菌种退化频发,背后竟是“亚临界污染”
在连续批次生产中,你是否发现菌株活性、代谢效率逐渐降低?
这是典型的
低剂量空气污染诱发菌株应激的表现:
- 微量杂菌干扰长期积累,诱导菌株产生“抗压”变异;
- 噬菌体反复低水平存在,引发菌株自我调控紊乱;
- 最终表现为:菌落性状变化、发酵产物减少、制剂效果下降。
如果不从“空气源头”断绝污染,这种退化不可逆、不可控。
痛点三:多点交叉作业,污染“偷偷扩散”
微生物工厂常在同一空间内开展多环节操作:
接种→ 扩培 → 发酵 → 浓缩 → 包装
操作人员流动频繁,物料、容器、设备传递频繁,如果空气不洁净,就会形成一条看不见的“污染传播链”。
- 一个污染点,影响五个环节;
- 一次轻忽,污染整条产线。
传统“固定紫外灯+送风过滤”的方式,无法实现
全时段、动态空气净化,也无法对抗流动中的噬菌体与杂菌传播。
✅ AEM-300空间灭菌器 —— 你真正需要的“空气防线”
为解决微生物实验与菌剂生产中的“空气污染死角”,
观微生物研发团队推出了AEM-300 空间灭菌器,专为农业微生物应用场景设计。
三大核心技术:
- 等离子体灭菌:强氧化清除空气中生物颗粒;
- 双波段UVC消杀:高强度紫外对噬菌体杀灭率>99.9%;
- HEPA+活性炭双重过滤:拦截颗粒杂质,吸附有害挥发物。
智能模块化控制:
- 可设定定时自动开启、循环灭菌;
- 可人机共存使用,无需关闭车间;
- 实时监控运行状态,异常报警提醒。
适用场景:
- 接种室、纯种保存区
- 发酵车间、小试车间
- 发酵罐周边工作区、包装灌装区
- 菌剂成品存放区